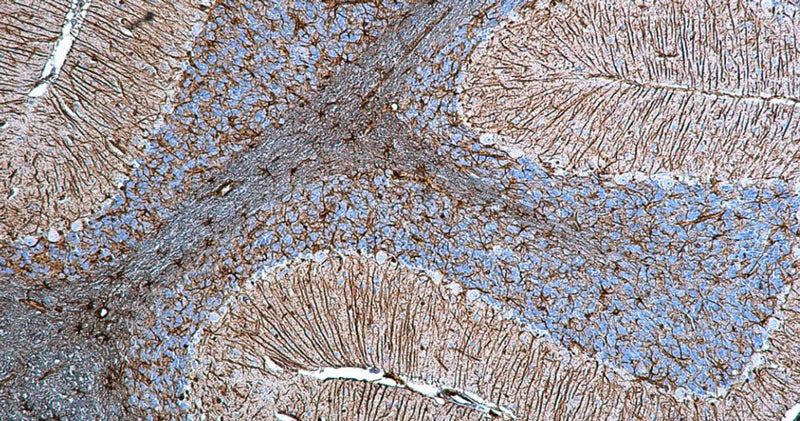
Immunohistochemistry for detection of GFAP in rat cerebellum using anti-GFAP antibody clone N206A/8 (Cat. 75-240) and Streptavidin/Biotin-ABC-Peroxidase Staining Kit (Cat. IH-8106). Tissue was fixed with 4% paraformaldehyde and paraffin embedded. Heat induced antigen retrieval was performed using citrate buffer (Cat. AR-6544) and then blocked with Immuno Protein Blocking Solution with Goat Serum (AR-6591). After washing, the primary antibody (Cat. 75-240) was incubated with the sample at a dilution of 1:500 at 4C overnight. Then the biotinylated goat anti-mouse secondary antibody was incubated with the tissue sample. Detection was made using Streptavidin/Biotin-ABC-Peroxidase Staining Kit (" target="_blank">Cat. IH-8106).

Ships: 1-2 business days
- Deparafinize FFPE tissue section is carried out as outlined in your protocol. Hydrate tissue with PBS or our Universal Immuno buffer.
- The tissue slides are immersed in this 1X solution and heated for 10-20 minutes at 100ºC; OR in pressure cooker for 3-5 minutes followed by cooling at room temperature for about 20 minutes.
- The tissue sections are ready for further IHC protocol.
Product Specific References
| PMID | Publication |
| 38145969 | Hwang, S., et al. 2023. Induction of Fatty Acid Oxidation Underlies DNA Damage-Induced Cell Death and Ameliorates Obesity-Driven Chemoresistance. Advanced science (Weinheim, Baden-Wurttemberg, Germany), e2304702. |
| 34924566 | Hwang, S., et al. 2021. Mitochondrial glutamine metabolism regulates sensitivity of cancer cells after chemotherapy via amphiregulin. Cell Death Discovery, 395. |
| 34631505 | Komoto, T.T., et al. 2021. Trans-chalcone suppresses tumor growth mediated at least in part by the induction of heme oxygenase-1 in breast cancer. Toxicological Research, 485-493. |
| 34294853 | Lertpatipanpong, P., et al. 2021. The anti-diabetic effects of NAG-1/GDF15 on HFD/STZ-induced mice. Scientific Reports, 15027. |
| 33828232 | Yang, J.M., et al. 2021. Long-term effects of human induced pluripotent stem cell-derived retinal cell transplantation in Pde6b knockout rats. Experimental and Molecular Medicine, 631-642. |
| 31776862 | Park, S.B., et al. 2020. Intestinal epithelial deletion of sphk1 prevents colitis-associated cancer development by inhibition of epithelial stat3 activation. Digestive Diseases and Sciences, 2284-2293. |